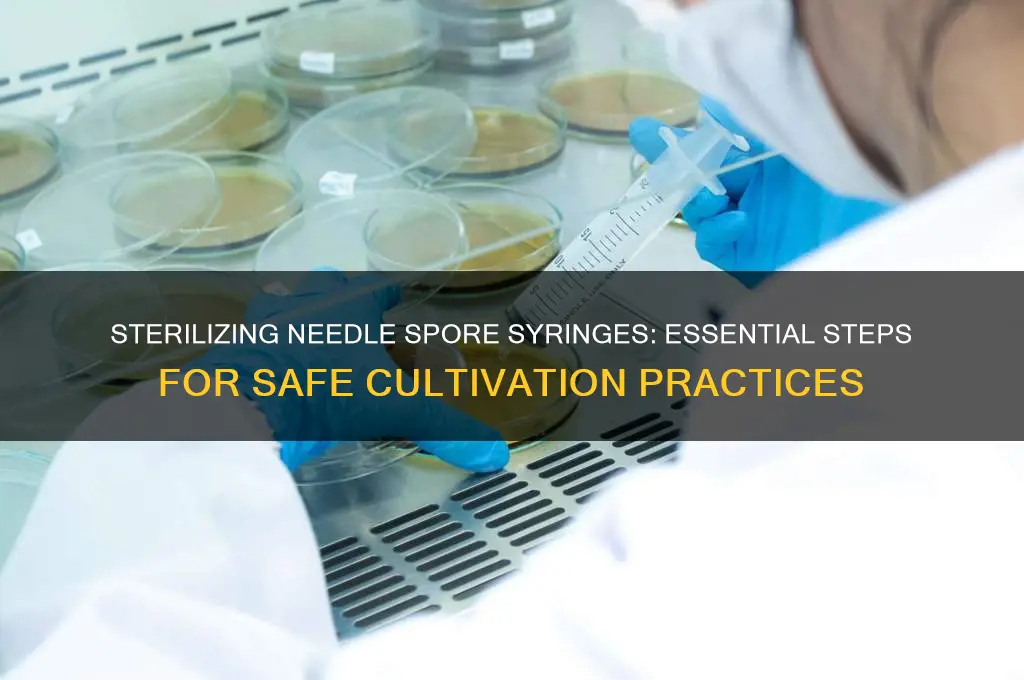
do i need to sterilize needle spore syringe

When considering whether to sterilize a needle or spore syringe, it's essential to prioritize safety and prevent contamination. These tools are commonly used in various applications, such as mycology, microbiology, or even tattooing, where maintaining a sterile environment is crucial to avoid infections or unwanted bacterial growth. Sterilization ensures that all microorganisms, including bacteria, fungi, and spores, are eliminated, reducing the risk of cross-contamination and ensuring the integrity of your work. Proper sterilization methods, such as using an autoclave, flame sterilization, or chemical disinfectants, should be employed to guarantee that the needle and spore syringe are free from any harmful pathogens before use.
| Characteristics | Values |
|---|---|
| Sterilization Requirement | Yes, sterilization is necessary to prevent contamination and ensure safety. |
| Method of Sterilization | Autoclaving is the most common and effective method; uses steam under pressure (121°C, 15-20 minutes). |
| Alternative Methods | Dry heat sterilization (160-170°C for 1-2 hours) or chemical sterilization (e.g., ethanol, bleach) can be used, but autoclaving is preferred. |
| Needle Sterilization | Needles must be sterilized separately or as part of the syringe assembly to ensure all components are free of microorganisms. |
| Spore Syringe Specifics | Spore syringes contain fungal spores, which are resistant to some sterilization methods; autoclaving is effective but must be done carefully to avoid damaging the spores. |
| Reuse of Syringes | Not recommended; single-use syringes and needles are safest to prevent cross-contamination. |
| Storage After Sterilization | Store in a clean, dry environment to maintain sterility until use. |
| Safety Precautions | Wear appropriate PPE (gloves, mask) during sterilization and handling to avoid exposure to heat, chemicals, or contaminants. |
| Validation of Sterilization | Use biological indicators (e.g., spore strips) to confirm autoclave effectiveness. |
| Legal and Ethical Considerations | Follow local regulations and guidelines for sterilization and disposal of medical equipment. |
Explore related products
What You'll Learn
- Sterilization Methods: Autoclave, pressure cooker, or chemical solutions for effective needle and syringe sterilization
- Contamination Risks: Unsterilized tools can introduce bacteria, fungi, or contaminants to spore syringes
- Reusable vs. Disposable: When to reuse needles/syringes and proper sterilization steps for safe reuse
- Sterility Testing: Methods to confirm tools are sterile before use in spore syringe work
- Storage Practices: How to store sterilized needles and syringes to maintain sterility over time

Sterilization Methods: Autoclave, pressure cooker, or chemical solutions for effective needle and syringe sterilization
Sterilizing needles and spore syringes is non-negotiable for anyone working with mycology or microbiology. Improper sterilization risks contamination, rendering your work useless or even dangerous. Three primary methods dominate the field: autoclaving, pressure cooking, and chemical solutions. Each has its strengths, limitations, and ideal use cases.
Autoclaves reign supreme in laboratory settings. These machines use saturated steam under pressure (typically 121°C for 15-20 minutes) to kill all microorganisms, including spores. This method is foolproof when executed correctly, making it the gold standard for sterilization. However, autoclaves are expensive and require access to specialized equipment, limiting their accessibility for hobbyists or those outside professional labs.
For those without an autoclave, a pressure cooker offers a viable alternative. Aim for a model with a gauge to monitor pressure and maintain 15 psi for 30 minutes at 121°C. This method, while less precise than autoclaving, can achieve effective sterilization if carefully monitored. Ensure your pressure cooker is dedicated solely to sterilization to avoid cross-contamination from food residues.
Regularly calibrate your pressure cooker's gauge and replace the gasket as needed to guarantee accurate pressure readings.
Chemical solutions like isopropyl alcohol (70% or higher) and hydrogen peroxide (3-6%) are convenient for surface disinfection but fall short of true sterilization. They are effective against most bacteria and fungi but may not eliminate all spores. For spore syringes, chemical disinfection is insufficient. However, for quick decontamination of needles before autoclaving or pressure cooking, a 10-minute soak in 70% isopropyl alcohol can be a useful preliminary step.
The choice of sterilization method depends on your resources, the level of sterility required, and the frequency of use. Autoclaves provide the most reliable results but demand significant investment. Pressure cookers offer a more accessible option with careful technique. Chemical solutions serve as a supplementary measure, not a standalone sterilization method. Remember, improper sterilization can jeopardize your entire project. Choose your method wisely and execute it meticulously.
Are Spores Harmful to Humans? Understanding Risks and Safety Tips
You may want to see also

Contamination Risks: Unsterilized tools can introduce bacteria, fungi, or contaminants to spore syringes
Unsterilized tools are a silent saboteur in the delicate process of handling spore syringes. Even microscopic bacteria, fungi, or contaminants introduced by a non-sterile needle can render an entire culture unusable. These organisms thrive in the nutrient-rich environment of a growing medium, quickly outcompeting the desired mycelium and leading to contamination.
A single contaminated syringe can spread rapidly, ruining multiple grow attempts and wasting valuable time and resources.
Consider the analogy of a garden. You wouldn't plant seeds in soil infested with weeds and expect a healthy harvest. Similarly, using unsterilized tools is like introducing weeds into your fungal garden. Bacteria and fungi, though microscopic, are incredibly resilient and opportunistic. They exploit any weakness in your sterile environment, multiplying exponentially and overwhelming the delicate mycelium you're trying to cultivate.
The consequences of contamination extend beyond a failed grow. Some contaminants can produce toxins harmful to both the mycelium and potentially to humans if consumed.
Sterilization is not an optional step; it's a fundamental pillar of successful spore syringe use. Common sterilization methods include autoclaving, which uses steam under pressure to kill all microorganisms, and flaming, where the needle is briefly passed through a flame to incinerate surface contaminants. While flaming is a quick method, it's less reliable than autoclaving, as it doesn't penetrate deep enough to eliminate all potential threats.
For those new to working with spore syringes, investing in an autoclave might seem daunting. However, the long-term benefits far outweigh the initial cost. Alternatively, partnering with a local lab or university that offers autoclave services can be a cost-effective solution. Remember, the goal is to create a completely sterile environment for your spores to thrive, and unsterilized tools are a critical breach in that defense.
Is Spore Available for Xbox 360? Compatibility and Alternatives Explained
You may want to see also

Reusable vs. Disposable: When to reuse needles/syringes and proper sterilization steps for safe reuse
Reusing needles and syringes is a practice that demands meticulous attention to safety, as improper sterilization can lead to infections, cross-contamination, or disease transmission. While disposable options are the gold standard in medical settings due to their single-use design, certain scenarios—such as home use for insulin administration or hormone therapy—may involve reusable equipment. The decision to reuse hinges on understanding the risks, adhering to strict sterilization protocols, and recognizing when disposable alternatives are non-negotiable.
When Reuse is Acceptable: A Narrow Window
Reusing needles or syringes is only advisable in controlled, non-medical environments where the user is the sole individual involved, such as self-administered insulin injections. Even then, reuse should be limited to a maximum of 3–5 times per needle, as repeated use dulls the tip, increasing tissue trauma and pain. Syringes, however, must be replaced after each use if not sterilized immediately. This practice is never recommended for shared equipment, as it eliminates the possibility of contamination from bloodborne pathogens like HIV or hepatitis.
Sterilization Steps: A Non-Negotiable Protocol
Proper sterilization requires a multi-step process to ensure all pathogens are eradicated. Begin by disassembling the syringe and needle, then clean with soap and warm water to remove visible debris. Submerge the components in a solution of 70% isopropyl alcohol for 20 minutes, followed by boiling in distilled water for 20 minutes. Alternatively, use an autoclave at 121°C (250°F) for 15–20 minutes. Allow items to air-dry on a sterile surface, and store in a sealed container until reuse. Note: Home sterilization methods are less reliable than professional techniques, so disposable options remain safer.
Cautions and Limitations: Where Reuse Fails
Reusing needles or syringes is never appropriate for injecting medications that require precise dosing, such as heparin or growth hormones, as residue can alter potency. Similarly, avoid reuse in individuals under 18, pregnant persons, or those with compromised immune systems, as their risk of infection is elevated. Always inspect equipment for defects—discard bent needles or cracked syringes immediately. Even with sterilization, microscopic damage or residual contaminants may persist, making disposables the safer choice in most cases.
While reusable needles and syringes can reduce waste and costs in specific contexts, their use requires unwavering adherence to sterilization protocols. For most individuals, the risks outweigh the benefits, making disposable options the prudent choice. When reuse is unavoidable, treat sterilization as a critical procedure, not an afterthought, and err on the side of caution by replacing equipment at the first sign of wear or doubt. Safety, not convenience, must guide this decision.
Bacillus Cereus Spores: Heat Sensitivity and Food Safety Concerns
You may want to see also
Explore related products
$5.49 $5.99

Sterility Testing: Methods to confirm tools are sterile before use in spore syringe work
Sterilization is non-negotiable when working with spore syringes, as contamination can ruin your entire project. While sterilizing your tools—needles, syringes, and containers—is crucial, confirming their sterility is equally vital. Sterility testing ensures that no viable microorganisms remain, providing confidence in the integrity of your work. Here’s how to approach it methodically.
Methods for Sterility Testing
One of the most reliable methods is the growth-based assay, where sterilized tools are exposed to a nutrient-rich medium under controlled conditions. For instance, place a sterilized needle or syringe in a sterile broth (e.g., tryptic soy broth) and incubate at 37°C for 7–14 days. If no turbidity or visible growth occurs, the tool is likely sterile. Alternatively, use agar plates: streak the surface of the tool across the medium and observe for colony formation. This method is cost-effective and accessible for home cultivators, though it requires patience and precision.
Rapid Testing Options
For those seeking quicker results, biological indicators (BIs) are a practical choice. BIs contain highly resistant spores (e.g., *Geobacillus stearothermophilus*) that, when inactivated, confirm effective sterilization. After sterilizing your tools, expose a BI to the same sterilization process. If the BI’s spores are killed (verified via a color-changing indicator or incubation test), your tools are likely sterile. This method is particularly useful for autoclave users, as BIs are designed to mimic the sterilization resistance of common contaminants.
Practical Tips and Cautions
When testing, avoid cross-contamination by handling tools with sterile gloves and working in a clean environment. If using growth-based methods, ensure the medium is sterile by autoclaving it beforehand. Be cautious of false negatives: some microorganisms may remain dormant or grow slowly, so extending the incubation period is advisable. For spore syringe work, where even a single contaminant can proliferate rapidly, thorough testing is indispensable.
Sterility testing is not just a precautionary step—it’s a cornerstone of successful spore syringe work. Whether you opt for traditional growth-based assays or rapid BI tests, the goal is the same: absolute confidence in your tools’ sterility. By integrating these methods into your workflow, you safeguard your project against contamination, ensuring consistent and reliable results.
Inoculating Agar with Spore Syringes: A Step-by-Step Guide
You may want to see also

Storage Practices: How to store sterilized needles and syringes to maintain sterility over time
Sterilized needles and syringes are only as effective as the care taken to maintain their sterility post-sterilization. Improper storage can reintroduce contaminants, rendering the sterilization process useless. To ensure long-term sterility, storage practices must prioritize cleanliness, protection from environmental factors, and adherence to best practices. This begins with understanding the materials involved: glass or plastic syringes, metal or plastic needles, and the packaging used to enclose them. Each material interacts differently with its environment, influencing how it should be stored.
Steps for Optimal Storage:
- Use Sterile Packaging: After sterilization, immediately transfer needles and syringes into sterile, sealed containers or individually wrapped pouches. Autoclave-safe paper or plastic-lined envelopes are ideal for single-use items.
- Maintain a Clean Environment: Store items in a designated, dust-free area with minimal foot traffic. Regularly clean storage shelves or cabinets with disinfectants to prevent airborne particles from settling.
- Control Temperature and Humidity: Store in a cool, dry place (room temperature, 20–25°C) with humidity below 60%. Excess moisture can compromise packaging integrity, while extreme heat may warp plastic components.
- Avoid Direct Sunlight: UV light can degrade plastics and weaken packaging seals. Keep storage areas away from windows or use opaque containers.
- Label and Date: Clearly mark containers with sterilization dates and expiration periods (typically 1–2 years for professionally sterilized items). Rotate stock to use older items first.
Cautions to Consider:
While sterilization ensures initial cleanliness, storage mistakes can reintroduce bacteria, fungi, or spores. For example, reusing opened packaging or storing items near chemicals can lead to cross-contamination. Additionally, overstacking containers can damage seals or puncture packaging. Always inspect items before use; discard any with compromised packaging or visible damage.
Practical Tips for Longevity:
For home users, consider vacuum-sealed storage bags for added protection against moisture and dust. Professionals should invest in sterile storage cabinets with HEPA filters to maintain a clean environment. Periodically audit storage practices to ensure compliance with sterilization standards, such as those outlined by the CDC or WHO. Proper storage is not just about preserving sterility—it’s about safeguarding health outcomes.
Maintaining sterility is a continuous process that extends beyond sterilization itself. By implementing rigorous storage practices, users can ensure that needles and syringes remain safe and effective for their intended use. Attention to detail in packaging, environment, and handling transforms storage from a passive step into an active safeguard against contamination.
Do Bacterial Spores Die? Unraveling Their Survival and Dormancy Mechanisms
You may want to see also
Frequently asked questions
Yes, it is crucial to sterilize the needle before use to prevent contamination of the spore syringe and ensure the integrity of the mushroom spores.
No, reusing a needle without proper sterilization risks introducing contaminants, which can ruin the spore solution and any subsequent cultivation attempts.
The most effective method is to flame-sterilize the needle by passing it through a flame (e.g., from a lighter or alcohol lamp) until it glows red, then allowing it to cool before use. Alternatively, use a sterile, single-use needle.

























